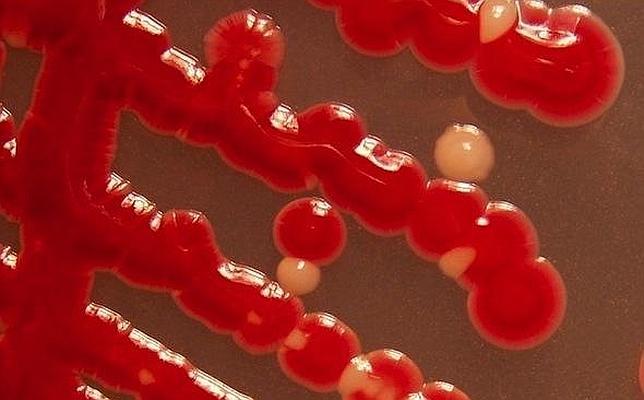
Descubren una bacteria común que podría vivir en Marte

Descubren una bacteria común que podría vivir en Marte
Se encuentra en la piel y el pelo de los seres humanos o en peces y plantas, y es capaz de resistir bajas presiones y temperaturas extremas
josé manuel nieves
Una bacteria muy común en la Tierra ha demostrado tener una extraordinaria resistencia y capacidad de adaptación. Tanto, que sería capaz de sobrevivir en Marte, a pesar de sus bajas presiones y su helada atmósfera de dióxido de carbono. El hallazgo se publicó en diciembre ... en la revista Proceedings y esta misma semana en Astrobiology.
La bacteria, llamada Serratia liquefaciens , puede encontrarse tanto en la piel, el pelo y los pulmones de los seres humanos como en peces, sistemas acuáticos y hojas y raíces de numerosas plantas. De hecho, y según asegura a Reuters Andrew Schuerger, microbiólogo de la Universidad de Florida, "está presente en un amplio rango de nichos ecológicos de temperaturas medias".
Los científicos se quedaron estupefactos al comprobar que esta bacteria, que normalmente vive y se desarrolla al nivel del mar (donde la presión es de mil milibares), era capaz de crecer en una cámara experimental de laboratorio en la que se había reducido la presión a sólo 7 milibares, la misma que reina en el Planeta Rojo.
"Fue una enorme sorpresa -asegura Schuerger-. No teníamos razón alguna para pensar que esta bacteria pudiera crecer a 7 milibares. Simplemente la incluímos en el estudio porque teníamos los cultivos a mano y porque estas especies habían sido recuperadas de naves espaciales".
Además de las preocupaciones que puede suscitar el hecho de que estos microbios "autoestopistas" puedan contaminar inadvertidamente Marte, el estudio abre las puertas a encontrar toda una variedad de formas de vida que tienen el potencial de crecer y desarrollarse allí.
Para sobrevivir en Marte, sin embargo, las bacterias necesitarían protejerse de alguna manera de la radiación ultravioleta a la que la superficie marciana está expuesta de forma continua, así como tener acceso a una fuente de agua, carbono orgánico y nitrógeno.
Recordemos que, precisamente, el rover Curiosity está ahora en Marte estudiando la química y las condiciones ambientales que podrían haber dado soporte, y quizá preservado, la vida en el Planeta Rojo. Y aunque los científicos no pretenden encontrar vida en el lugar de aterrizaje, sí que esperan descubrir si el planeta que más se parece a la Tierra tiene, o tuvo, los ingredientes necesarios para el desarrollo de la vida.
Por eso, los esfuerzos para encontrar en la Tierra microbios que puedan sobrevivir en Marte se ha convertido en un importaante objetivo para la Ciencia. Aunque esos esfuerzos se han centrado hasta ahora en el estudio de extremófilos, criaturas que viven en los ambientes más fríos, secos, ácidos y extremos de nuestro planeta.
A nadie se le había ocurrido, sin embargo, probar con organismos mucho más "normales", como es el caso de la bacteria Serratia liquefaciens. Pero las sorpresas no acabaron ahí. En efecto, Schuerger y su equipo sometieron a las mismas condiciones a dos extremófilos (además de a otras 23 bacterias comunes) y ninguna de ellas logró sobrevivir a un experimento en el que, además de bajar la presión hasta los 7 milibares, se reprodujeron las bajas temperaturas y la atmósfera rica en dióxido de carbono de Marte.
Puestas a prueba
Experimentos posteriores llevados a cabo con otras 10.000 bacterias recuperadas a entre 12 y 21 metros de profundidad en el subsuelo siberiano sacaron a la luz otras seis especies (todas ellas miembros del género Carnobacterium ), que podrían sobrevivir y multiplicarse en la cámara de simulación marciana del Laboratorio de Ciencias Espaciales de la Vida de la NASA en Florida.
El siguiente paso será el de apretar un poco más las tuercas a estas bacterias para ver cómo responden en condiciones incluso más hostiles, como unos altos niveles de salinidad y radiación, unidos a la reducción de la cantidad de agua disponible. Por supuesto, también se llevarán a cabo nuevos estudios para profundizar en el metabolismo y la genética de la bacteria común Serratia liquefaciens, que tanto ha sorprendido a los investigadores.
"En la búsqueda de vida en otros planetas -afirma Schuerger- tenemos que empezar por algo a lo que tengamos acceso. Y no tenemos bacterias marcianas con las que podamos experimentar. Por lo menos no por ahora, por lo que intentamos averiguar si algunos de nuestros microorganismos tienen la capacidad de sobrevivir en otros lugares".
"Si nunca lográramos encontrar un microbio capaz de sobrevivir a las condiciones de otro planeta -prosigue el científico- eso implicaría que la vida podría no haber existido nunca en ese otro mundo".
Descubren una bacteria común que podría vivir en Marte
Noticias relacionadas
- ¿Sería la vida en Marte parecida a la de la Tierra?
- Criaturas extremófilas podrían vivir en planetas no habitables
- El Curiosity no puede confirmar aún la existencia de material orgánico en Marte
- Marte y otros candidatos para la vida
- Curiosity, en busca de vida primitiva en Marte
- Empieza la carrera para encontrar ADN en Marte
- ¡Sorpresa! Marte está lleno de agua
Esta funcionalidad es sólo para suscriptores
Suscribete
Esta funcionalidad es sólo para registrados
Iniciar sesiónEsta funcionalidad es sólo para suscriptores
Suscribete